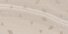

Код товара: DW9RES21
Гарантия 1 год при предъявлении чека
-
Производитель:
-
Тип:Декор
-
Формат плитки, мм:249x500
-
Толщина, мм:7.5
-
Тип поверхности:Глянцевая
-
Край:Нет
-
Коэффициент противоскольжения:—